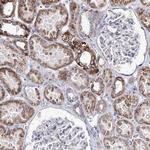
ORP5 Antibody in Immunohistochemistry (Paraffin) (IHC (P))

Search
Invitrogen
ORP5 Polyclonal Antibody
{{$productOrderCtrl.translations['antibody.pdp.commerceCard.promotion.promotions']}}
{{$productOrderCtrl.translations['antibody.pdp.commerceCard.promotion.viewpromo']}}
{{$productOrderCtrl.translations['antibody.pdp.commerceCard.promotion.promocode']}}: {{promo.promoCode}} {{promo.promoTitle}} {{promo.promoDescription}}. {{$productOrderCtrl.translations['antibody.pdp.commerceCard.promotion.learnmore']}}
产品信息
PA5-58507
种属反应
宿主/亚型
分类
类型
抗原
偶联物
形式
浓度
规格
纯化类型
保存液
内含物
保存条件
运输条件
RRID
产品详细信息
Immunogen sequence: FSLCPPSSTP QKVDPRKLTR NLLLSGDNEL YPLSPGKDME PNGPSLPRDE GPPTPSSATK VPPAEYRLCN GSDKECVSPT ARVTKKETLK
Highest antigen sequence identity to the following orthologs: Mouse - 76%, Rat - 78%.
靶标信息
This gene encodes a member of the oxysterol-binding protein family, a group of intracellular lipid receptors that play a key role in the maintenance of cholesterol balance in the body. Most members contain an N-terminal pleckstrin homology domain and a highly conserved C-terminal OSBP-like sterol-binding domain. This gene has been shown to be imprinted, with preferential expression from the maternal allele only in placenta. Transcript variants encoding different isoforms have been identified.
仅用于科研。不用于诊断过程。未经明确授权不得转售。
篇参考文献 (0)
生物信息学
蛋白别名: DKFZp586H1719; FLJ31948; FLJ42929; ORP-5; ORP5; OSBP-related protein 5; OSBP11; Oxysterol-binding protein homolog 1; oxysterol-binding protein homologue 1; Oxysterol-binding protein-related protein 5; unnamed protein product
基因别名: KIAA1534; OBPH1; ORP5; OSBPL5
UniProt ID: (Human) Q9H0X9
Entrez Gene ID: (Human) 114879